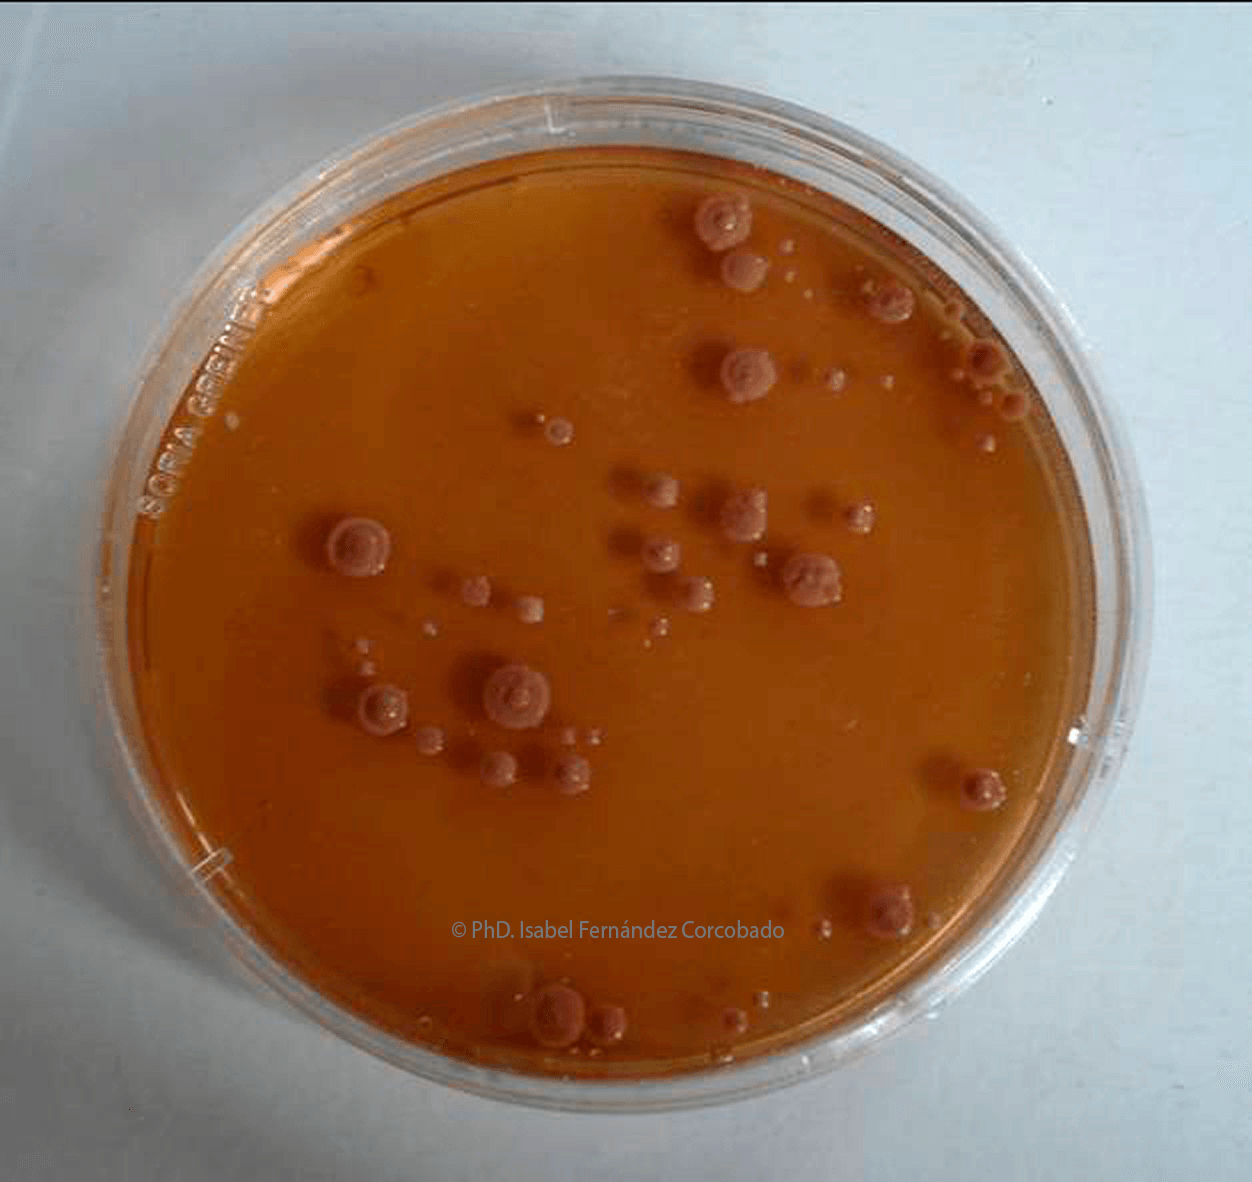

PUBLICATIONS
-
EurekAlert - American Association for the Advancement of Science (AAAS)
Researchers develop a new technique to date forensic death based on corpse microorganisms Universidad de Granada References: Miguel C. Botella López. Isabel Fernández Corcobado. Laboratory of Anthropology of the University of Granada. Eulogio Bedmar Gómez. Zaidín Experimental Station - CSIC - Granada.Button -
New technique to date forensic death based on corpse microorganisms
UGR Channel University of GranadaButton -
4th International Conference on Forensic Research & Technology September 28-30, 2015 Atlanta, USA
OMICS International Microbiological Chronotanatodiagnosis. The innovative way to determine the Time of Death Isabel Fernández Corcobado Innovative Science Forensic’s Office, SpainButton -
Conference on Innovative Criminalistics Techniques for Crime Scene Analysis
Innovative Science Forensic's Office (ISFO)Button
NATIONAL CENTER FOR OPEN AND UNSOLVED CASES